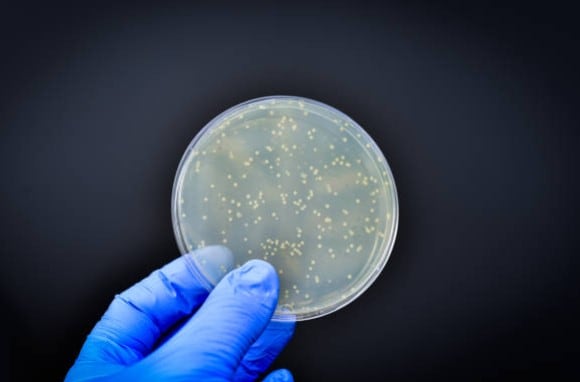
Imagen representativa de la listeria
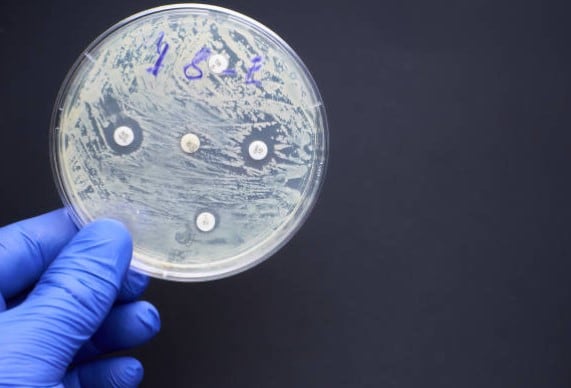
Imagen representativa de la listeria

La detección de un nuevo brote de listeria ha encendido las alarmas en Estados Unidos, luego que se registrará 20 personas hospitalizadas y un deceso.
Sin embargo, ¿qué es la listeria?
¿Qué es la listeria y por qué enciende las alarmas en los Estados Unidos?
De acuerdo de Salud de New York, la listeria es una infección provocada por Listeria monocytogenes. La cual surge por consumir alimentos contaminados.
Pese a que cualquiera le puede dar la listeria, las personas con mayor riesgos son:
- las mujeres embarazadas
- los recién nacidos
- las personas de edad avanzada
- las personas con sistemas inmunológicos
La listeria, enciende las alarmas en los Estados Unidos, ya que se presentaron 22 personas infectadas en 10 estados del país, luego de que viajarán a Florida el mes pasado.
Lo anterior porque la listeria está ampliamente distribuida en la naturaleza y se les puede encontrar en el agua y tierra.
Los animales infectados también pueden ser fuentes de transmisión, pues pueden transmitirlo por distintos métodos como heces.
Cabe destacar que otra fuente de infección es la ingesta de animales infectados (a través de alimentos), como puede ser:
- la leche sin pasteurizar
- vegetales crudos contaminados
- carne contaminada
- alimentos procesados como quesos blancos, perros calientes y fiambres
¿Cuáles son los síntomas de la listeria?
Según expresa el Departamento de Salud de New York, los síntomas de la listeria son:
- fiebre
- dolor de cabeza intenso
- náuseas
- vómitos
- confusión
- pérdida de equilibrio
- convulsiones
¿Cómo puede se puede prevenir el contagio de listeria?
Ya que le organismo se encuentra expandido en la naturaleza, lo mejor que se puede hacer para protegerse de la listeria es tener medidas sanitarias básicas, tales como:
- Consumo de productos lácteos pasteurizados
- Comer carnes cocidas
- Lavarse bien las manos antes de preparar alimentos
En el caso de las mujeres embarazadas y las personas con sistemas inmunológicos débiles se sugiere evitar estos alimentos, al igual que quesos blandos y salchichas crudas.
Por otro lado, aunque el riesgo de la listeria es bajo en alimentos de delikatessen es bajo; se recomienda que las personas previamente mencionadas eviten estos o recaliente bien las carnes antes de comerlos.


